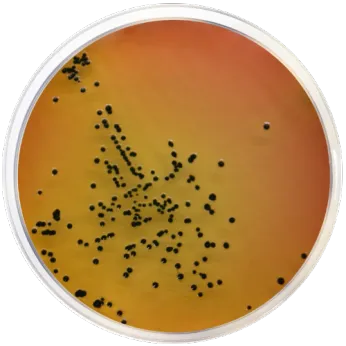

LABORATORIOS CONDA SA
Exhibitors
Information
A leading European manufacturer of culture media.
Founded in 1960 we are one of the main European manufacturers of dehydrated culture media for microbiology and molecular biology, which positions us today as a leading international privately held company.
From our factory in Madrid, Spain we export to more than 130 countries all over the world, directly and through authorized distributors. Our wide distribution network along with our highly skilled staff, quality and specialized product range, are the keys to our success.
Halls
Hall 3
Country Pavilion
Yes
Country of Origin
Spain
Nature of Business
Manufacturer